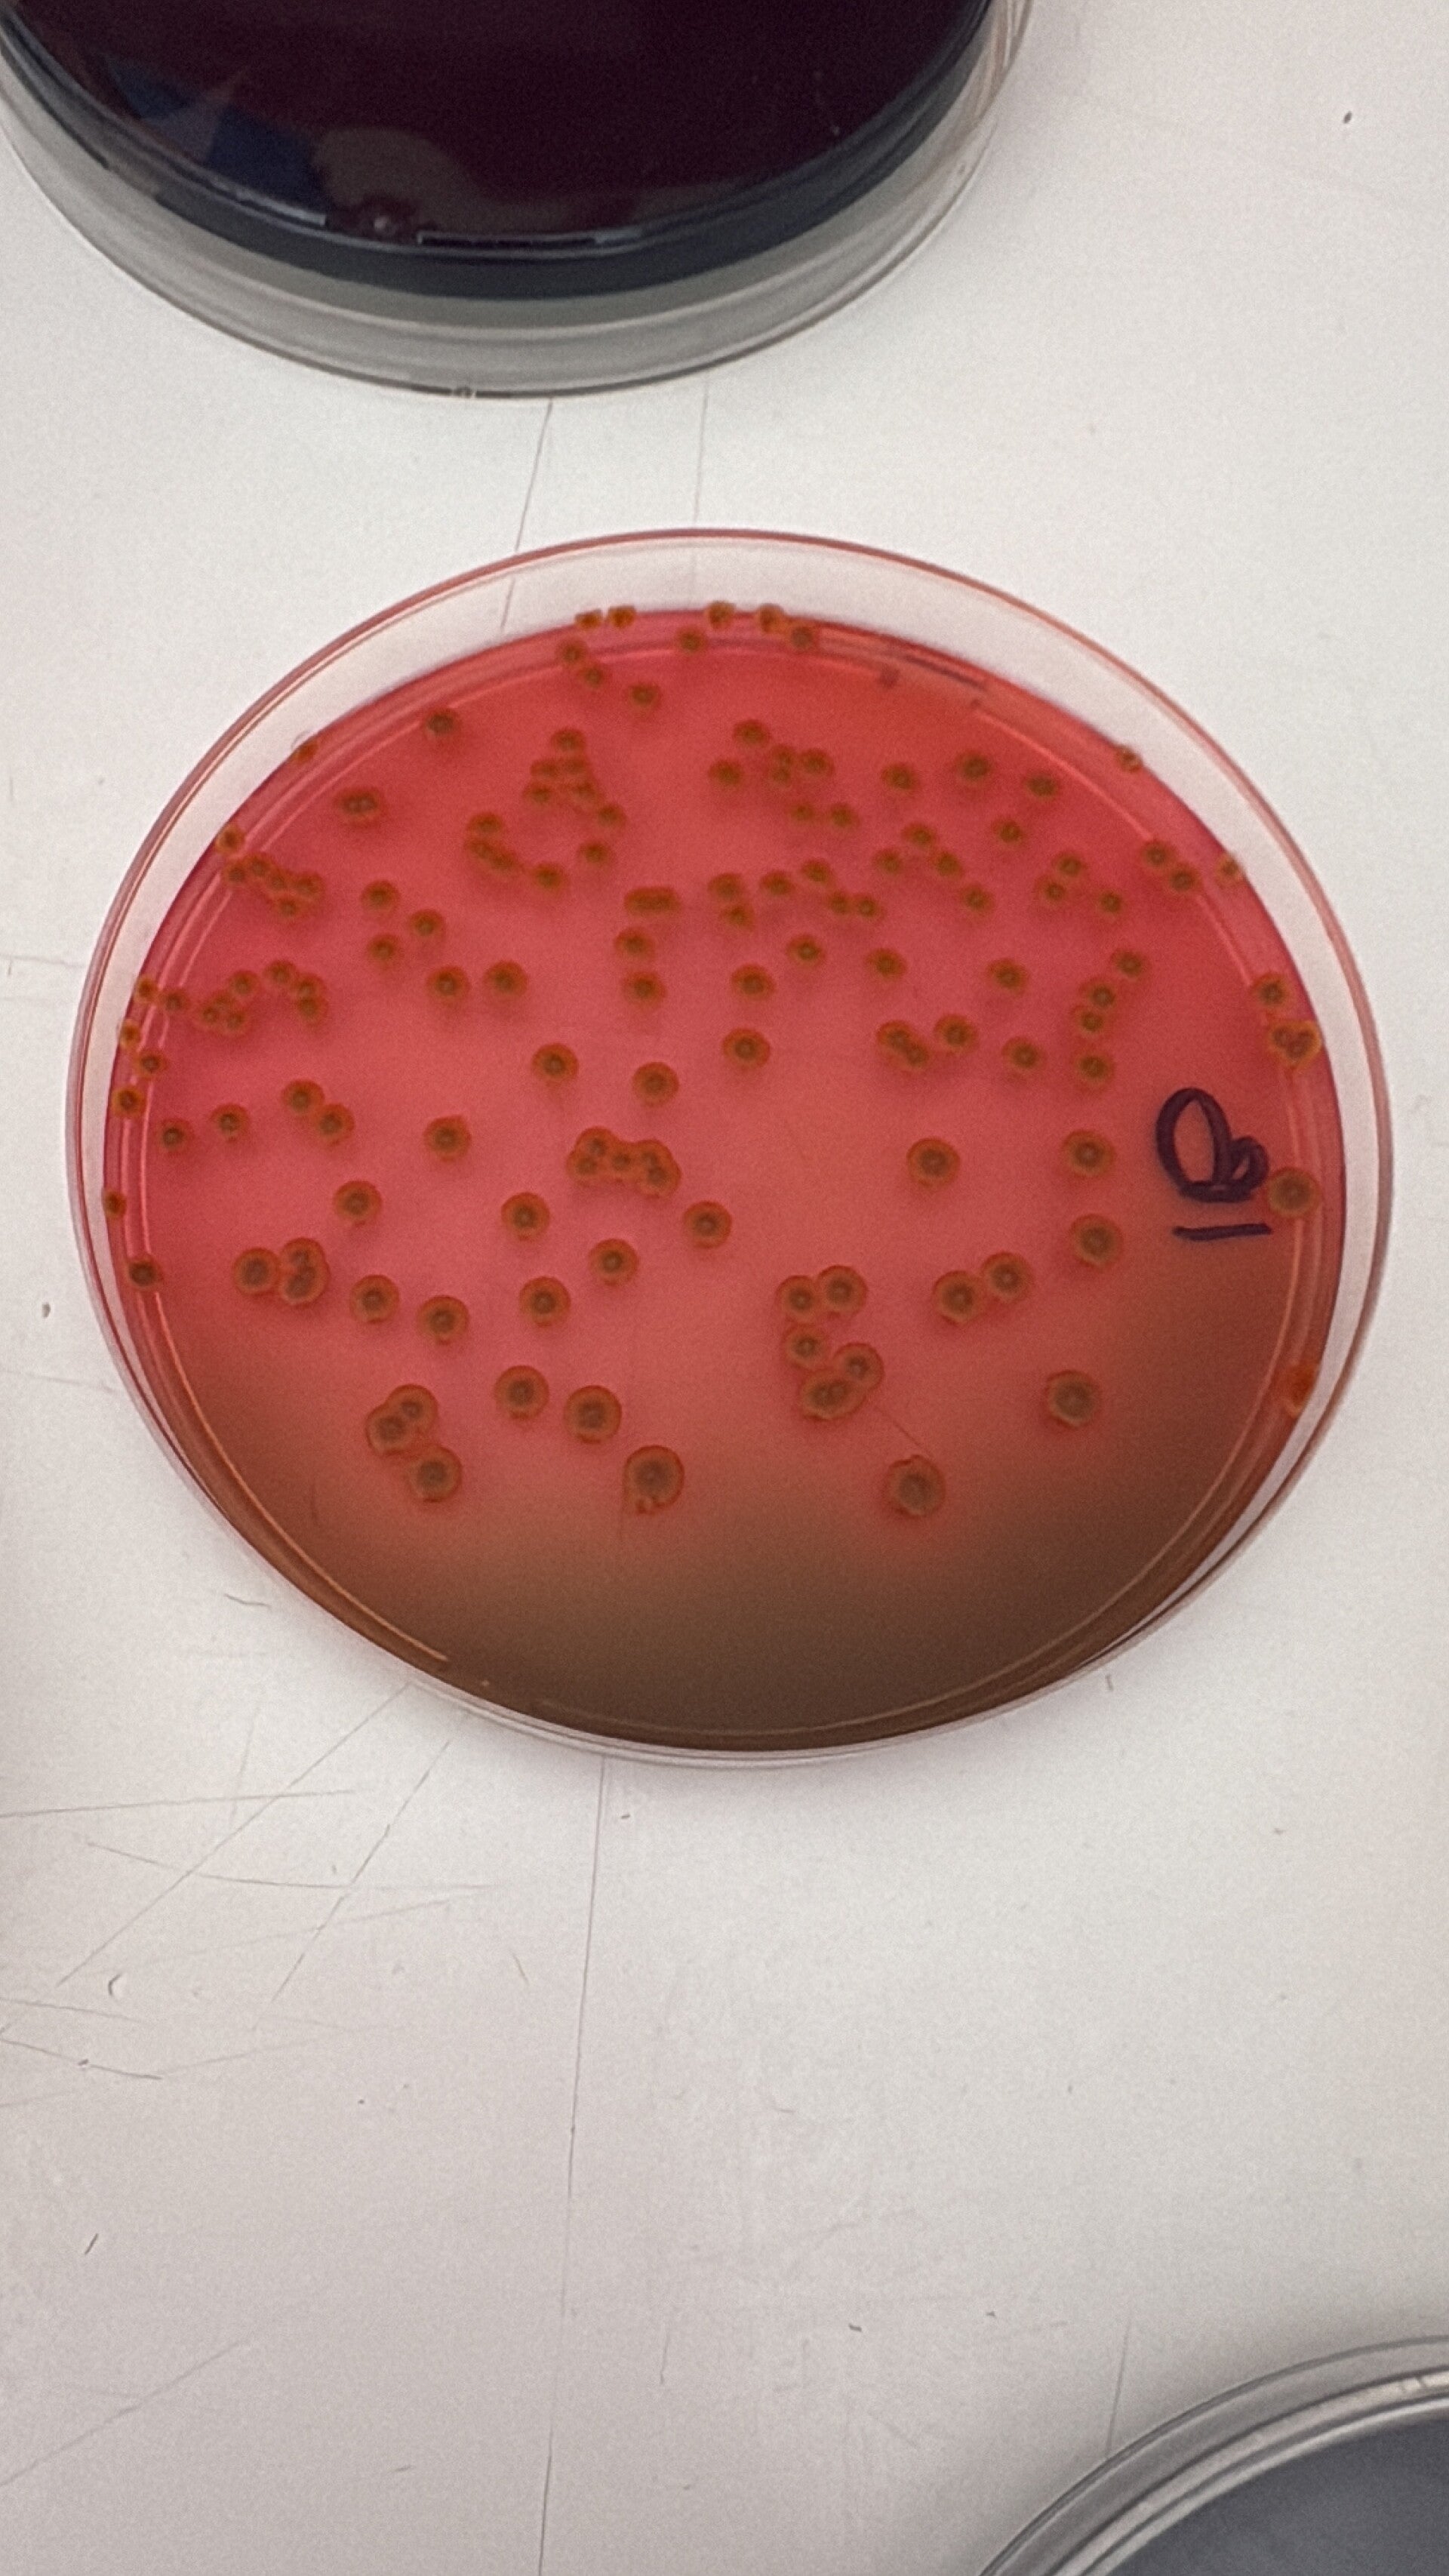

Privacy e Sicurezza
Ci impegniamo a proteggere la tua privacy e a garantire la massima sicurezza dei dati forniti durante la consulenza. Seguiamo rigorose politiche di protezione dei dati conformi alle normative vigenti.contratto privacy.docx

Riservatezza delle Informazioni
Tutte le informazioni e i dati condivisi durante la consulenza sono trattati con la massima riservatezza. Garantiamo la protezione e la non divulgazione delle informazioni sensibili.celex%3a32016r0679%3ait%3atxt.pdf
Hai bisogno di consulenza su microbiologia del vino o della birra?
Contattaci oggi stesso per ricevere supporto personalizzato per le tue esigenze.